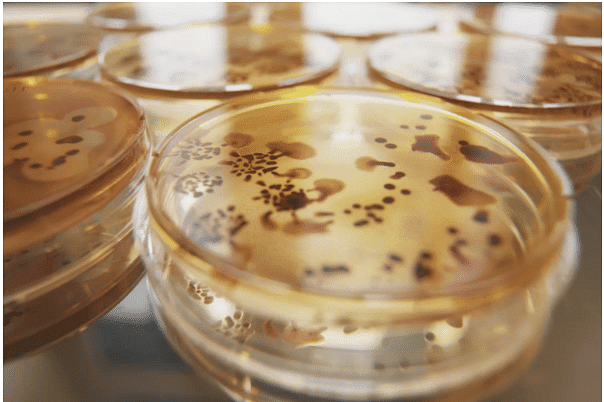

Phases of Bacterial Growth | Biology and Biochemistry for MCAT PDF Download
Bacteria require certain conditions for growth, and these conditions are not the same for all bacteria. Factors such as oxygen, pH, temperature, and light influence microbial growth. Additional factors include osmotic pressure, atmospheric pressure, and moisture availability. A bacterial population's generation time, or time it takes for a population to double, varies between species and depends on how well growth requirements are met.
Phases of the Bacterial Growth Cycle

In nature, bacteria do not experience perfect environmental conditions for growth. As such, the species that populate an environment change over time. In a laboratory, however, optimal conditions can be met by growing bacteria in a closed culture environment. It is under these conditions that the curve pattern of bacterial growth can be observed.
The bacterial growth curve represents the number of live cells in a bacterial population over a period of time.
- Lag Phase: This initial phase is characterized by cellular activity but not growth. A small group of cells are placed in a nutrient rich medium that allows them to synthesize proteins and other molecules necessary for replication. These cells increase in size, but no cell division occurs in the phase.
- Exponential (Log) Phase: After the lag phase, bacterial cells enter the exponential or log phase. This is the time when the cells are dividing by binary fission and doubling in numbers after each generation time. Metabolic activity is high as DNA, RNA, cell wall components, and other substances necessary for growth are generated for division. It is in this growth phase that antibiotics and disinfectants are most effective as these substances typically target bacteria cell walls or the protein synthesis processes of DNA transcription and RNA translation.
- Stationary Phase: Eventually, the population growth experienced in the log phase begins to decline as the available nutrients become depleted and waste products start to accumulate. Bacterial cell growth reaches a plateau, or stationary phase, where the number of dividing cells equal the number of dying cells. This results in no overall population growth. Under the less favorable conditions, competition for nutrients increases and the cells become less metabolically active. Spore forming bacteria produce endospores in this phase and pathogenic bacteria begin to generate substances (virulence factors) that help them survive harsh conditions and consequently cause disease.
- Death Phase: As nutrients become less available and waste products increase, the number of dying cells continues to rise. In the death phase, the number of living cells decreases exponentially and population growth experiences a sharp decline. As dying cells lyse or break open, they spill their contents into the environment making these nutrients available to other bacteria. This helps spore producing bacteria to survive long enough for spore production. Spores are able to survive the harsh conditions of the death phase and become growing bacteria when placed in an environment that supports life.
Bacterial Growth and Oxygen
Campylobacter jejuni, shown here, is a microaerophilic organism requiring reduced levels of oxygen. C. jejuni is the bacterium which causes gastroenteritis.
Campylobacter jejuni, shown here, is a microaerophilic organism requiring reduced levels of oxygen. C. jejuni is the bacterium which causes gastroenteritis.
- Bacteria, like all living organisms, require an environment that is suitable for growth. This environment must meet several different factors that support bacterial growth. Such factors include oxygen, pH, temperature, and light requirements. Each of these factors may be different for different bacteria and limit the types of microbes that populate a particular environment.
- Bacteria can be categorized based on their oxygen requirement or tolerance levels. Bacteria that can not survive without oxygen are known as obligate aerobes. These microbes are dependent upon oxygen, as they convert oxygen to energy during cellular respiration. Unlike bacteria that require oxygen, other bacteria can not live in its presence. These microbes are called obligate anaerobes and their metabolic processes for energy production are halted in the presence of oxygen.
- Other bacteria are facultative anaerobes and can grow with or without oxygen. In the absence of oxygen, they utilize either fermentation or anaerobic respiration for energy production. Aerotolerant anerobes utilize anaerobic respiration but are not harmed in the presence of oxygen. Microaerophilic bacteria require oxygen but only grow where oxygen concentration levels are low. Campylobacter jejuni is an example of a microaerophilic bacterium that lives in the digestive tract of animals and is a major cause of foodborne illness in humans.
Bacterial Growth and pH
 Helicobacter pylori are microaerophilic bacteria found in the stomach. They are neutrophiles that secrete an enzyme that neutralizes stomach acid.
Helicobacter pylori are microaerophilic bacteria found in the stomach. They are neutrophiles that secrete an enzyme that neutralizes stomach acid.
- Another important factor for bacterial growth is pH. Acidic environments have pH values that are less that 7, neutral environments have values at or near 7, and basic environments have pH values greater than 7. Bacteria that are acidophiles thrive in areas where the pH is less than 5, with an optimal growth value close to a pH of 3. These microbes can be found in locations such as hot springs and in the human body in acidic areas such as the vagina.
- The majority of bacteria are neutrophiles and grow best in sites with pH values close to 7. Helicobacter pylori is an example of a neutrophile that lives in the acidic environment of the stomach. This bacterium survives by secreting an enzyme that neutralizes stomach acid in the surrounding area.
- Alkaliphiles grow optimally at pH ranges between 8 and 10. These microbes thrive in basic environments such as alkaline soils and lakes.
Bacterial Growth and Temperature
 New Zealand's Champagne Pool is a hot spring that contains a community of thermophilic and acidophilic microorganisms whose distribution relates to the temperature and chemical environment.
New Zealand's Champagne Pool is a hot spring that contains a community of thermophilic and acidophilic microorganisms whose distribution relates to the temperature and chemical environment.
- Temperature is another important factor for bacterial growth. Bacteria that grow best in cooler environments are called psycrophiles. These microbes prefer temperatures ranging between 4°C and 25°C (39°F and 77°F). Extreme psycrophiles thrive in temperatures below 0°C/32°F and can be found in places such as arctic lakes and deep ocean waters.
- Bacteria that thrive in moderate temperatures (20-45°C/68-113°F) are called mesophiles. These include bacteria that are part of the human microbiome which experience optimum growth at or near body temperature (37°C/98.6°F).
- Thermophiles grow best in hot temperatures (50-80°C/122-176°F) and can be found in hot springs and geothermal soils. Bacteria that favor extremely hot temperatures (80°C-110°C/122-230°F) are called hyperthermophiles.
Bacterial Growth and Light
 Cyanobacteria (blue) are photosynthesizing bacteria that are found in most habitats where water is present. Several spores (pink) are also seen.
Cyanobacteria (blue) are photosynthesizing bacteria that are found in most habitats where water is present. Several spores (pink) are also seen.
- Some bacteria require light for growth. These microbes have light-capturing pigments that are able to gather light energy at certain wavelengths and convert it to chemical energy. Cyanobacteria are examples of photoautotrophs that require light for photosynthesis. These microbes contain the pigment chlorophyll for light absorption and oxygen production through photosynthesis. Cyanobacteria live in both land and aquatic environments and can also exist as phytoplankton living in symbiotic relationships with fungi (lichen), protists, and plants.
- Other bacteria, such as purple and green bacteria, do not produce oxygen and utilize sulfide or sulfur for photosynthesis. These bacteria contain bacteriochlorophyll, a pigment capable of absorbing shorter wavelengths of light than chlorophyll. Purple and green bacteria inhabit deep aquatic zones.
|
129 videos|60 docs|24 tests
|















